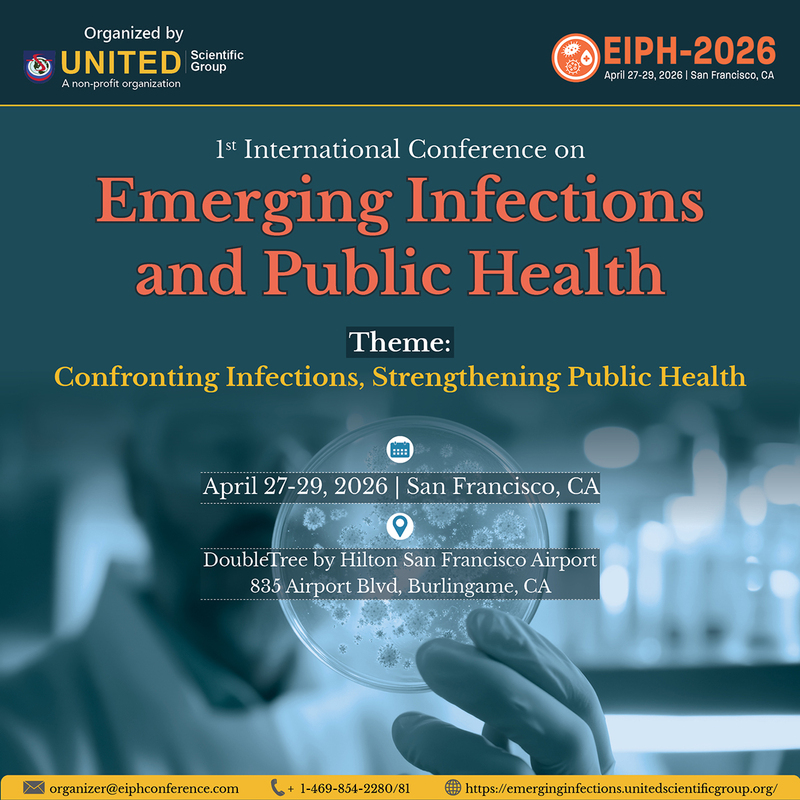

1st International Conference on Emerging Infections and Public Health (Communities - Education)

Item ID 133554252 in Category: Communities - Education
1st International Conference on Emerging Infections and Public Health | |
Hosted in the innovation hub of San Francisco, California, the 1st International Conference on Emerging Infections and Public Health (EIPH-2026) scheduled to take place from April 27–29, 2026 promises to be a transformative gathering of thought leaders committed to advancing global health through science, policy, and collaboration. This three-day international event will focus on the multifaceted dimensions of infectious diseases, from molecular biology and epidemiology to health systems preparedness and global policy coordination. The conference will explore critical areas such as the surveillance of novel pathogens, strategies to counteract drug resistance, and the development of broad-spectrum antivirals and vaccines. Special emphasis will be placed on lessons learned from recent pandemics, the integration of digital health tools into disease tracking, and equity in access to healthcare solutions. By combining high-level scientific sessions with practical case studies and interactive networking forums, the conference aims to spark innovation, bridge knowledge gaps, and catalyze partnerships that can lead to measurable change in the global fight against infectious diseases. EIPH-2026serves as a key gathering for professionals in the field of infectious diseases. Clinicians, researchers, epidemiologists, scientists, healthcare providers, and emerging scholars will come together to share cutting-edge research, groundbreaking innovations, and practical solutions aimed at tackling the most pressing infectious disease challenges of our time. Experience hands-on workshops and live demos showcasing the newest diagnostic tools, rapid testing technologies, and next-gen therapeutics. Discover how these innovations are being translated from lab to clinic. We are excited to have you join us at the EIPH-2026, where innovation meets collaboration in the fight against infectious diseases. For more information, please visit: https://emerginginfections.unitedscientificgroup.org/ Please contact at Email: organizer@eiphconference.com Phone: +1-469-854-2280/81 Recommended: Infectious Diseases Conferences 2026 | Infectious Diseases Conference 2026 | Infectious Diseases Meetings 2026 | Infectious Diseases Events 2026 | Infectious Diseases Congress 2026 | Public Health Conferences 2026 | Public Health Conference 2026 | Infection Conferences 2026 | Infection conference 2026 | Infectious Diseases Congresses 2026 | Infectious Diseases Virtual Congress 2026 | Infectious Diseases Webinars 2026 | Infectious Diseases Virtual Events 2026 | Infectious Diseases Online Conferences 2026 | Emerging Infections 2026 | Infectious Diseases Seminars 2026 | Public Health Congresses 2026 | Public Health Congress 2026 | Public Health Events 2026 | Public Health Webinars 2026 | Public Health Virtual Events 2026 | Public Health Online Congresses 2026 | Public Health Online conferences 2026 | Infectious Diseases Summit 2026 | Public Health Summit 2026 | Public Health Online Summit 2026 | Infection Online meetings 2026 | Infection Virtual Meetings 2026 | Global Infectious Diseases Conferences 2026 | World Infectious Diseases Conferences 2026 | International Infectious Diseases Conferences 2026 | Global Public Health Conferences 2026 | World Public Health Conferences 2026 | International Public Health Conferences 2026 | |
| Related Link: Click here to visit item owner's website (0 hit) | |
| Target State: All States Target City : All Cities Last Update : May 30, 2025 10:33 AM Number of Views: 90 | Item Owner : Archana Madasu Contact Email: Contact Phone: +1-469-854-2280/81 |
| Friendly reminder: Click here to read some tips. | |
© 2025 USNetAds.com
GetJob.us | CANetAds.com | UKAdsList.com | AUNetAds.com | INNetAds.com | CNNetAds.com | Hot-Web-Ads.com | USAOnlineClassifieds.com
2025-11-12 (0.433 sec)